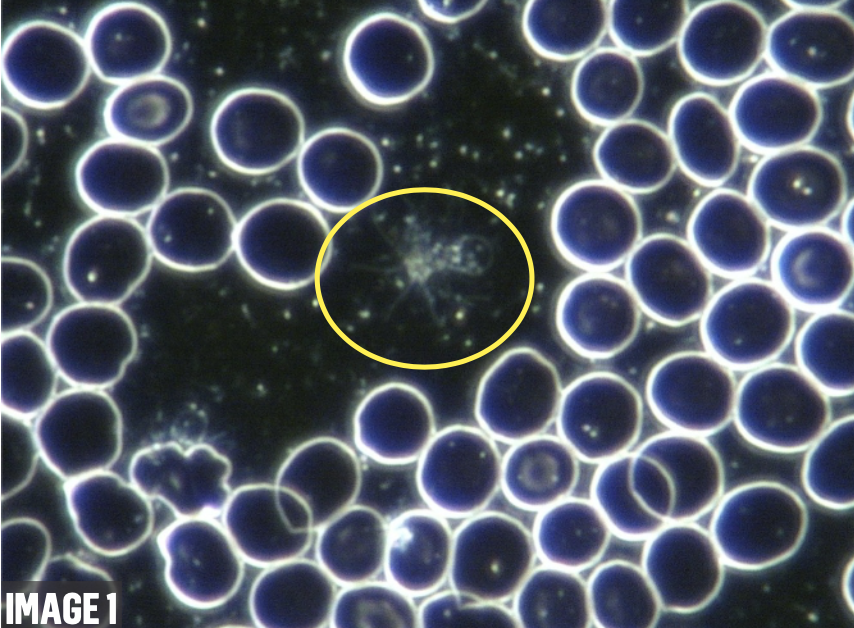
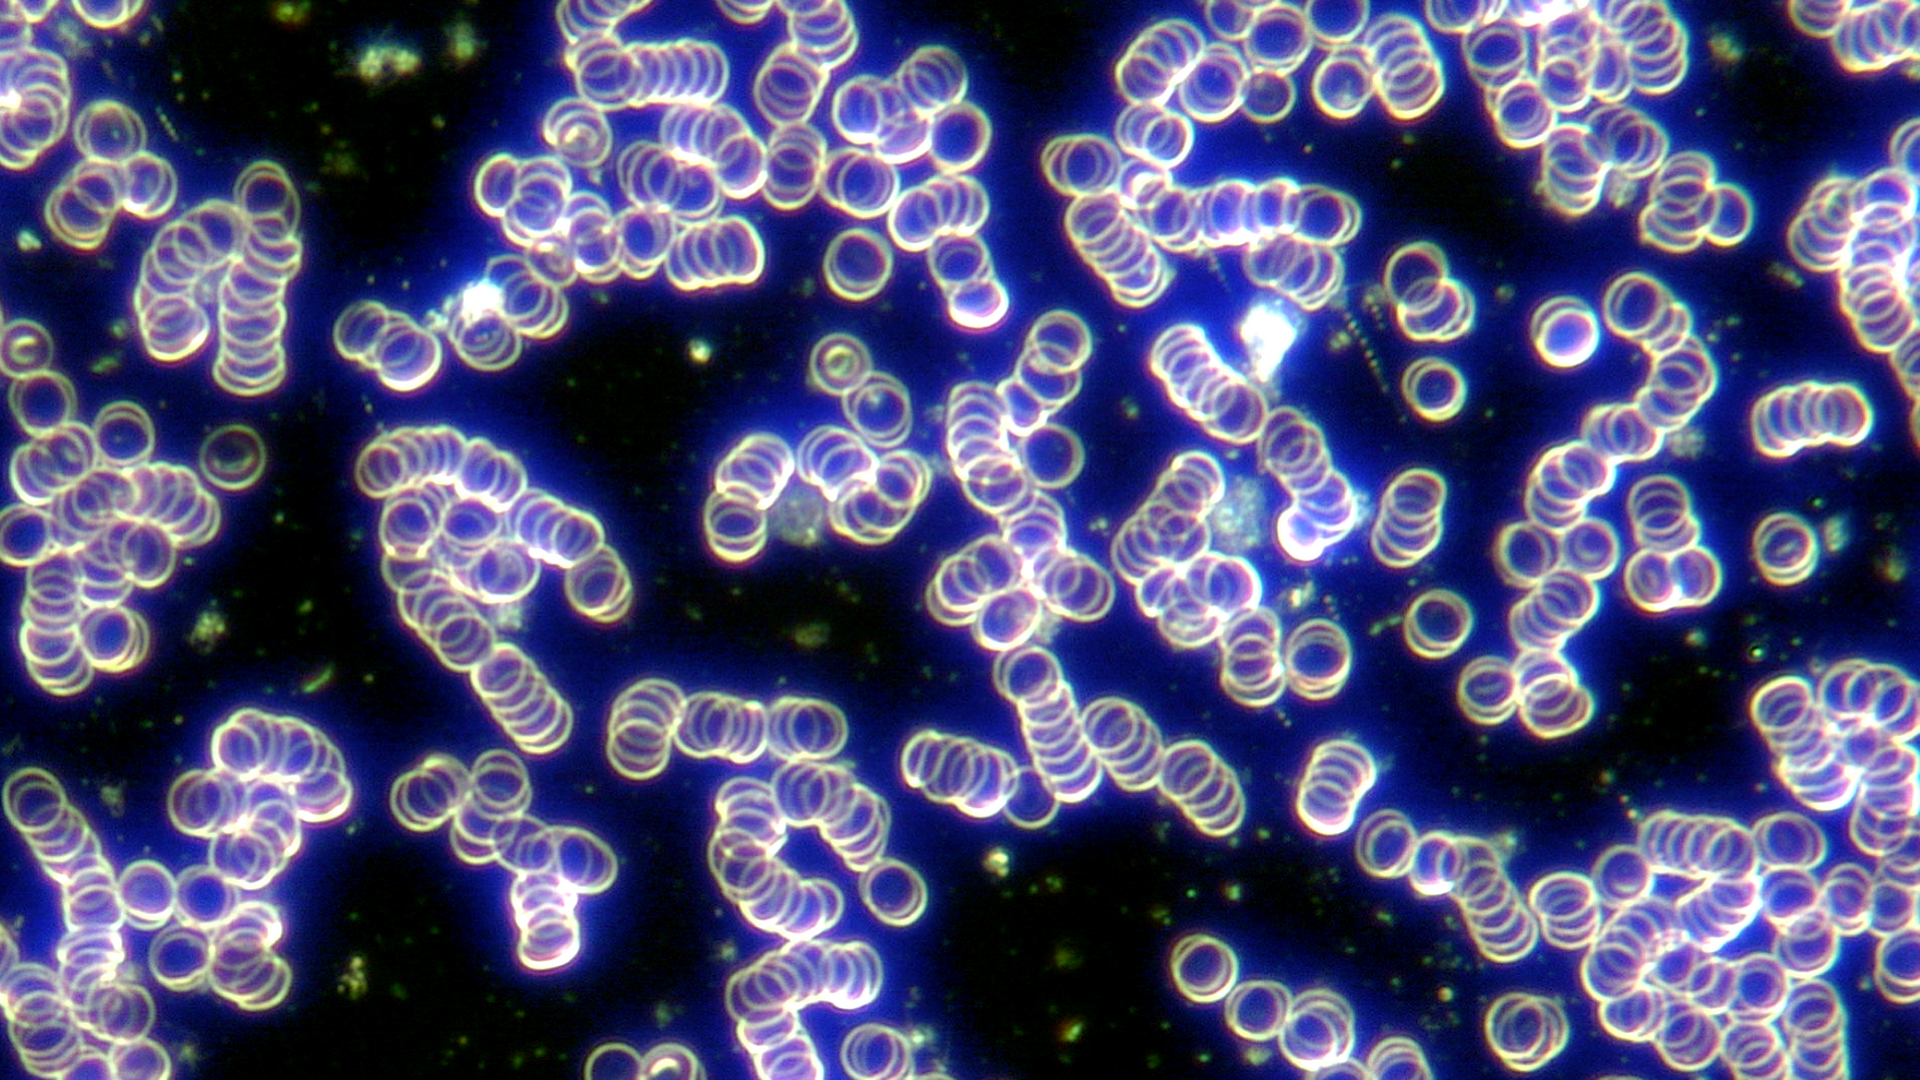
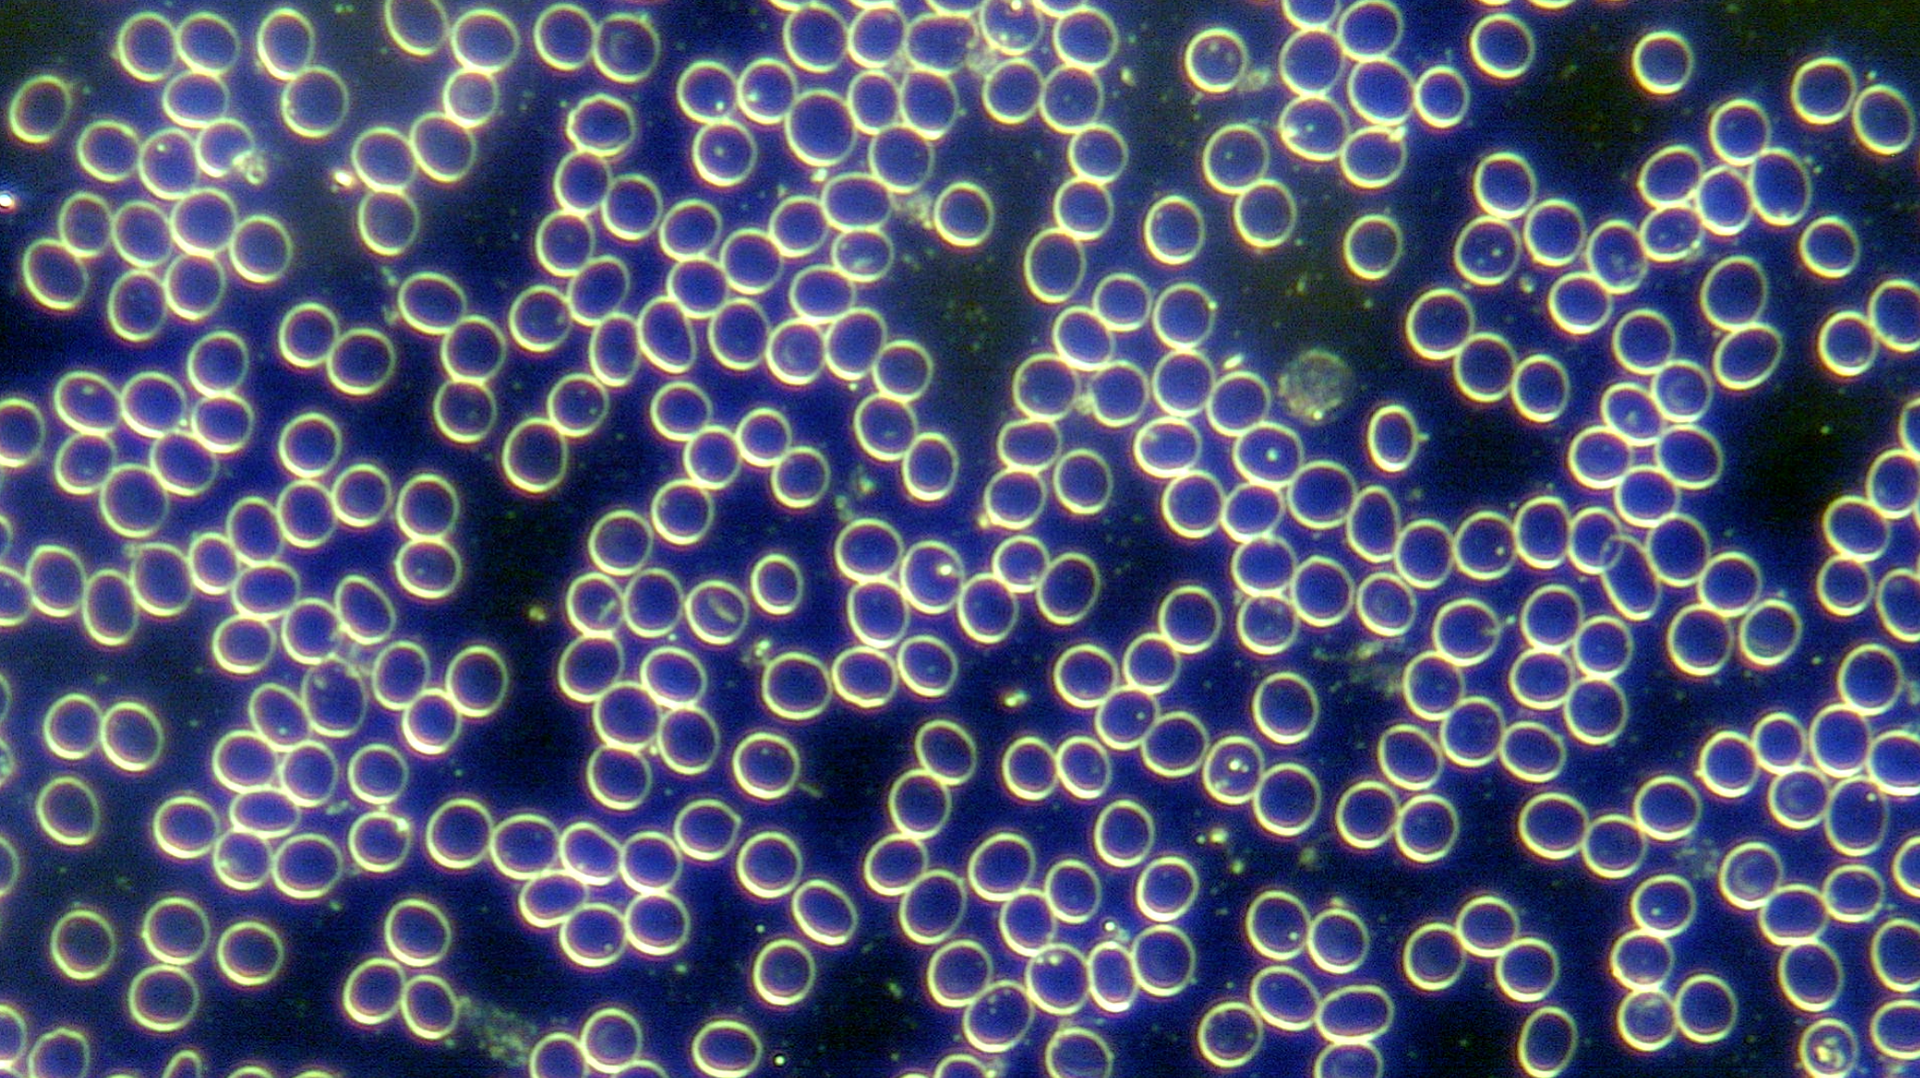

Scientific Research and Product Validation for Health Brands and Industry Professionals
Bringing Clarity and Confidence to Health Products
This service is dedicated to bringing clarity and truth to the world of nutritional and health products. Addressing a critical gap in the market, this service specialises in validating product claims to ensure they meet their promised efficacy. Through thorough research, including clinical studies, that may involve blinded, placebo-controlled methods, this service supports companies and the public in understand the genuine benefits and origins of the products. With a commitment to transparency and rigorous analysis, this approach provides consumers with confidence and safety, while equipping companies with solid evidence of their product's effectiveness. The ultimate goal is to foster a more informed and confident marketplace in the health and nutrition industry.
Cutting-Edge Research Services
Personalised Study Framework
Reveal new dimensions for your product to elevate your brand's success.
Each study is uniquely crafted to suit your specific product and align with your objectives, ensuring the research supports your brand's vision. With over 25 years of hands-on experience utilising diagnostic testing, you are provided with support and guidance on selecting the most effective tests, interpreting the results, and understanding their implications.
This service incorporates third-party diagnostic laboratory tests complimented by live blood analysis, if indicated, within a customised study framework involving a cohort of participant test subjects. Each study is designed to highlight the unique aspects of your product, ensuring results align seamlessly with your goals. For example, when evaluating a product addressing inflammation and congestion, findings can be substantiated through standard blood markers such as CRP or ESR, as well as visually observed changes through live blood analysis. This dual approach ensures comprehensive and impactful validation of your product's efficacy.
Leveraging Proven Expertise in Product Research
Through collaborative research with various companies, the potential of products has been consistently demonstrated at the cellular level. Whether highlighting the exceptional circulatory benefits of oxygen water, the protection properties of EMF protection products, the detoxifying capabilities of nutraceuticals, or the rejuvenating effects of ionic detoxification foot baths, findings vividly illustrate the biological transformative potential of these products.
Initial Pilot Studies
In initial pilot studies, a rigorous approach is taken to ensure compliance and accuracy throughout the process. In some cases, the study coordinator may choose to participate as a test subject to gain firsthand insights into the products and protocols being tested. This participation is conducted anonymously or under pseudonym to maintain objectivity, with full disclosure and approval from the sponsoring company. By doing so, the coordinator can better assess the the study's design and implementation, ensuring that any progression to a Phase 2 study with a larger sample size is conducted with the highest level of precision and reliability.
This practice adheres to ethical research guidelines in the UK, as well as MHRA regulations and industry-specific standards, ensuring transparency and trust. The goal is to produce robust, reliable data that accurately reflects the efficacy of the products and protocols under review. Every effort is made to uphold the highest standards of integrity and ethical compliance throughout the research process.
Providing Access to World-Leading Laboratories
Unlock the potential of your product with our comprehensive analysis services.
We partner with the world’s leading research laboratories, with an extensive portfolio of over 300 tests.
Our objective is to address a crucial question:
Does your product truly fulfil its intended purpose and effectively demonstrate its designed functionality?
Validate your product's health benefits by demonstrating its impact on blood and cells.
Through a comprehensive study design, third party diagnostic laboratory tests provide credible, quantitative analysis to answer these questions and prove out your product's impact on various aspects of health. Additionally, utilising Darkfield Microscopy Live Blood Analysis, alongside diagnostic lab results, allows us to visually demonstrate the effects of your product on cells and enables us to offer a unique service and marketing advantage.
Elevate your product's credibility and highlight its distinctive features through our in-depth analysis.
The efficacy of your product is supported by compelling laboratory results, featuring detailed graphs. These results serve as powerful tools, presenting indisputable evidence that not only substantiates the positive impact of your product but also significantly enhances its credibility, providing a substantial advantage in the market place.
Diagnostic laboratory tests provide credible data on aspects such as
- systemic toxicity: heavy metals, plastics, chemicals
- nutritional values
- blood markers
- hormone levels
- neurotransmitter levels
Live Blood Analysis
This service explores your product's potential through Live Blood Analysis. We delve into the intricate realm of live blood, the life-enriching river that sustains every cell in your body.
Through
Live Blood Analysis we observe and confirm your product's impact on various aspects of the blood:
- Red blood cell flow (zeta potential)
- White blood cell function (phagocytosis)
- Oxidative stress (echinocytes)
- Coagulation and congestion (erythrocyte aggregation / platelet activation)
- Systemic inflammation (fibrin)
- B12 and folate status (macrocytes / microcytes / anisocytosis)
- Iron status (annulocytes)
- Cell membrane health (poikilocytes)
- Leaky gut (protoplasts / platelet activation with fermentation)
- Cardiovascular health (schizocytes and chylomicrons)
The efficacy of your product is supported by compelling microscopic evidence, featuring
micrographs and video footage.
Consider the compelling before-and-after images showcasing the transformative effects of an EMF protection card on a test subject's blood. These visuals, along with videos, serve as a potent tool presenting indisputable evidence that not only substantiates the positive impact of a product but also significantly enhances credibility, providing a substantial advantage in sales.
The above micrograph image on the left illustrates a blood condition known as Rouleaux, where cells stack together due to 20-minute exposure to EMF from an iPad. In this state, blood is compromised in it's ability to efficiently deliver oxygen and nutrients to tissue, and remove waste products. The image on the right depicts the same person's blood after an equal duration of EMF exposure, but with protection from the Bio Photonic Range of products, the blood cells are no longer stuck and stacked and are now flowing freely to do their vital job.
Your Product as Art
Microscopic Masterpieces
Showcase your Product’s Visual Appeal
It's not just a product, it's a Masterpiece waiting to be discovered.
Capturing images through a microscope offers a service of unparalleled value and beauty. With a wealth of experience collaborating with diverse companies over the years, I've skilfully crafted evocative imagery. Whether capturing the harmonious allure of organic skincare or the vibrant essence of a flower remedy, our work unveils a unique perspective, providing your product with a distinctive and competitive edge.
The above micrograph image on the left captures the beauty of a flower essence blended with a natural food state multi-nutrient, revealing stunning patterns reminiscent of Klimt's renowned painting "The Kiss." It beautifully mirrors the synergy when two compatible elements unite.
One is micrometers, the other is light years. Both are natural phenomena with undeniable pattern similarities.
The above micrograph image on the left beautifully portrays clustered nano-sized zeolite crystals, renowned for their potent capacity to extract heavy metals from the body. Intriguingly, it bears a striking resemblance to a Hubble image capturing a constellation of stars in space (known as globular cluster NGC 121), drawing attention to the mirroring of microcosmic and macrocosmic worlds within these two images. This parallel is further accentuated by the fact that, like zeolite crystals, stars exhibit a drawing-in effect on surrounding particles.
Crystallography
Where Words are Born in Ice
What Deep Insights Does Your Product Reveal?
Delve into your product’s inherent communication through the lens of Crystallography
Introducing a groundbreaking method, known as Crystallography, which reveals complex patterns akin to decoding a hidden language. By capturing patterns known as hydroglyphs through Crystallography, we offer unparalleled insights into your product, providing information and intrigue beyond your expectations.
Whether analysing your product directly through crystallography or exploring how it influences water and the messages it imparts, our approach delivers a unique perspective that grants your product a distinctive and competitive edge.
Based on the work of Veda Austin, Caroline Mansfield has advanced the technique of Crystallography through her unique approach to observing products, refined over many years of experience.
As water transforms into ice, it not only solidifies but also reveals intricate patterns that can be interpreted as a visual language of symbols and words.
This profound concept highlights the detailed patterns formed during the crystallisation process. Crystallography examines the structure of water molecules in various states, showcasing the unique properties of ice and the dynamics of water molecules as they freeze.
By applying this technique to your product, we can uncover how it influences water, revealing distinctive patterns and insights into its effects.
The Crystallographic analysis of "Love in Essence" by Nahaia Active Organics, a spray formulated blend of 8 unique shell essences designed to enhance the positive and increase energetic love, revealed profound messages. The Fern Hexagon pattern signifies gratitude received with love, while the Feather pattern represents vibration. Together, these symbols convey a powerful message: the product embodies a vibration of love infused with deep gratitude.
The Crystallography analysis of "MasterPeace" by Human Consciousness Support revealed its profound essence. Formulated with patent pending Zeolite-Z and Sea Plasma this powerful detox support product aids in removing toxins embedded deep in tissue. The heart glyph signifies love, the line ladders represent ascension, the stairway denotes the flow of information, and the winter trees symbolize change. Together, these symbols encapsulate the product’s core purpose: holistic transformation.
Important Note About Research Scope
Studies are conducted within the framework of a naturopathic practitioner approach and are not designed to replicate large-scale clinical trials. The emphasis is on delivering practical and meaningful insights into product efficacy through personalised diagnostic testing and holistic methodologies. Backed by over 25 years of experience, this approach provides valuable data to support product development and validation, tailored to align with specific objectives.
GET IN TOUCH
Registered Office: 85 Great Portland Street, London, England, W1W 7LT
info@carolinemansfield.com